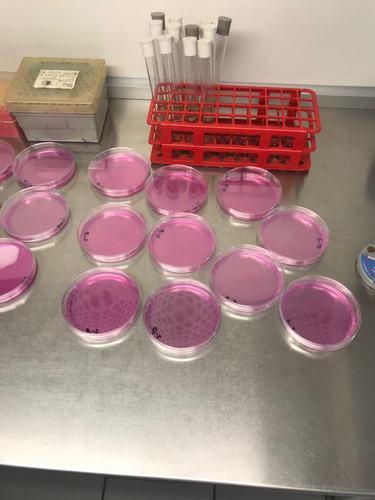

Dieta z karpiem przygotowana przez naukowców - dla sportowców olimpijskich
Wysoka zawartość składników odżywczych w mięsie karpia skłoniła zespół naukowy do zaprojektowania przekąski przeznaczonej dla sportowców z wykorzystaniem dodatków z ryby. Pozytywne wyniki prowadzonych badań pozwalają myśleć, że baton energetyczny może być wykorzystany przez polskich sportowców na igrzyskach olimpijskich.
Czytaj dalej
Zawodowi sportowcy wielokrotnie podkreślają, że ich największym marzeniem jest zdobycie medalu olimpijskiego. Niesamowite wyniki osiągane przez profesjonalistów zapoczątkowały modę na aktywny tryb życia. Coraz więcej osób regularnie ćwiczy i odżywia się w racjonalny sposób, aby poprawiać rezultaty. Zespół pod kierownictwem dr inż. Joanny Tkaczewskiej z Katedry Przetwórstwa Produktów Zwierzęcych na Wydziale Technologii Żywności Uniwersytetu Rolniczego w Krakowie po wielu badaniach naukowych opracował przekąskę z dodatkiem mięsa karpia. – Dzięki wysokiej wartości odżywczej i zawartości składników biologicznie aktywnych (m.in. BCAA, witaminy antyoksydacyjne i kwasy omega-3) to idealne rozwiązanie dla osób uprawiających sport wyczynowo oraz podejmujących aktywność fizyczną regularnie – wyjaśnia dr inż. Tkaczewska. Projekt przynosi obiecujące wyniki, niewykluczone więc, że przekąska będzie stosowana przez reprezentantów Polski na zbliżających się igrzyskach olimpijskich.

Ach ten stres
Uprawianie sportu na najwyższym światowym poziomie równoznaczne jest ze wzmożonym zapotrzebowaniem organizmu na energię, składniki odżywcze oraz regulujące. Nieodzownym elementem jest prawidłowa dieta dostosowana do treningów, okresów regeneracji, a także przemyślane żywienie około wysiłkowe. Ponadto sportowcy narażeni są na stres oksydacyjny. Powstaje on na skutek zaburzeń równowagi między produkcją wolnych rodników tlenowych a zdolnością komórki do ich eliminacji. Każdego dnia w wyniku procesów przemiany materii, wysiłku fizycznego oraz wskutek oddziaływania szkodliwych czynników zewnętrznych w organizmie powstają reaktywne cząsteczki zwane wolnymi rodnikami. Aby pomóc organizmowi je zneutralizować podjęto próbę stworzenia przekąski z karpia o charakterze prozdrowotnym (tzw. snack food). – Z uwagi na fakt, że mięso karpia jest doskonałym źródłem kwasów omega-3, wapnia, aminokwasów rozgałęzionych i antyoksydacyjnych bioaktywnych peptydów stało się jasne, że to może być element wsparcia dla ludzi aktywnych – tłumaczy dr inż. Tkaczewska.
.jpg)
Wspierająca przekąska
Zaprojektowany produkt spożywczy skierowany jest do sportowców wyczynowych oraz osób regularnie uprawiających sport, niebędących członkami klubów sportowych, ale przywiązujących dużą wagę do aspektów związanych ze zdrowym trybem życia. Warto podkreślić, że ze względu na wysoką wartość odżywczą, proporcje składników odżywczych zgodne z rekomendacjami i fakt, że jest on naturalny, nie ma konieczności tworzenia ograniczeń wiekowych. – W skład otrzymanej przekąski wchodzą m.in. daktyle, orzechy, nasiona, mięso karpia oraz hydrolizat białkowy, również pochodzący z karpia. Ten snack food cechuje się wysoką akceptowalnością przez konsumentów, wysoką wartością odżywczą oraz długim terminem przydatności – zaznacza kierująca projektem.

Czytaj również: Korona Runmageddonu 2019 - zdobyta przez drużynę Czerwonych Nosków
Przekąska charakteryzuje się wysoką zawartością węglowodanów, będących podstawowym źródłem energii dla pracujących mięśni i pozwalających utrzymać stały poziom glukozy we krwi przed rozpoczęciem aktywności fizycznej, a także oszczędzić rezerwy glikogenu znajdujące się w wątrobie i mięśniach. Dodatkowo proteiny z mięsa karpia korzystnie wpływają na szybszą syntezę nowych białek, w szczególności w przypadku treningów trwających do 45 minut. Należy zaznaczyć, że na rynku brakuje produktów spożywczych, wykazujących tak szerokie spektrum działania, a rosnąca świadomość osób aktywnych fizycznie wpływa na większe zapotrzebowanie na tego typu środki spożywcze.
Szeroki zakres projektu
W trakcie realizacji projektu opracowano technologię wytwarzania hydrolizatów białkowych z żelatyny karpiowej, cechującej się wysokimi właściwościami przeciwutleniającymi. Ponadto otrzymany hydrolizat ma właściwości antyhipertensyjne in vitro (może mieć zdolność do obniżania ciśnienia krwi). Uzyskany preparat może być stosowany nie tylko do zaprojektowanej przekąski, ale też jako dodatek do żywności funkcjonalnej, w celu otrzymania produktów obniżających stres oksydacyjny w organizmie człowieka.
Wesprzyj projekt, weź udział w testach
W trakcie trwania projektu zrealizowano 8 zadań badawczych. Aktualnie prowadzone są badania kliniczne na Akademii Wychowania Fizycznego w Krakowie z udziałem ludzi wyczynowo uprawiających sport, których koordynatorem jest dr Małgorzata Morawska. Do wzięcia udziału w badaniu zapraszani są mężczyźni w wieku 18-40 lat, podejmujący aktywność fizyczną. Sportowcy poddawani są testom wysiłkowym (test stopniowany i test ekscentryczny) w celu nasilenia stresu oksydacyjnego w organizmie. – Pierwsze wyniki wskazują na obiecujące działanie przekąski w organizmie ludzkim, szczególnie ocena wpływu na status oksydacyjny krwi sportowców – mówi dr inż. Tkaczewska. Jeśli wszystko pójdzie zgodnie z planem, produkt zostanie skomercjalizowany i wejdzie na rynek. Być może polscy sportowcy skorzystają z przekąski już na zbliżających się igrzyskach olimpijskich.
_fot. A. Morawska.jpg)
Projekt realizowany jest ze środków Narodowego Centrum Badań i Rozwoju w ramach programu Lider VII.
Czytaj również: Czy współczesny biegacz może się obyć bez maski antysmogowej
POLSKA AKWAKULTURA
Akwakultura, czyli chów i hodowla ryb i innych organizmów wodnych, odgrywa kluczową rolę w zaopatrzeniu rosnącej liczby ludności na świecie w bezpieczną i zdrową żywność, przy optymalnym wykorzystaniu zasobów naturalnych i minimalizowaniu negatywnego wpływu na środowisko. W Polsce akwakultura dostarcza obecnie ponad 45 000 ton ryb rocznie. Jedną z tradycyjnych gałęzi akwakultury jest hodowla karpi w stawach ziemnych, prowadzony na ziemiach polskich od XII-XIII wieku. Do dnia dzisiejszego akwakultura karpi pozostaje produkcją ekstensywną, prowadzoną metodami, które nawiązują do pierwotnie stosowanych w średniowieczu. Hodowla ryb w stawach ziemnych poza produkcją wysokiej jakości żywności oferuje usługi na rzecz środowiska naturalnego: kształtując i wzbogacając lokalną różnorodność biologiczną, retencjonując wodę w okresie wiosennym i letnim, redukując zawiesiny oraz biogeny w wodzie i wpływając pozytywnie na mikroklimat. Polscy hodowcy zaoferują konsumentom w 2019 r. ok. 19 000 ton karpi.
Projekt finansowany ze środków Funduszu Promocji Ryb
Komentarze
Czytaj też…
Czytaj na forum
- gdzie kupujecie akcesoria samochodowe? Liczba postów: 56 Grupa: Trudne tema... Odkąd zaczęłam bardziej interesować się detailingiem, zwracam uwagę nawet na drobne detale podczas mycia samochodu. Wiele ciekawych wskazówek znalazłam na autok...
- Automatyzacja marketingu Liczba postów: 13 Grupa: Trudne tema... Poczytaj sobie https://interaktywnie.com/ - na pewno o tym pisali tam nie raz. A oprócz tego mają tam dobrą bazę agencji, które mogą Ci pomóc marketingowo ;)
- Czy automatyzacja procesów biznesowych w przedsięb... Liczba postów: 5 Grupa: Aktualności Automatyzacja procesów biznesowych to dziś nie przewaga konkurencyjna – to konieczność. MP Technology https://mp-technology.com/ wspiera firmy we wdrażaniu rozw...
- Firmy sprzątające - opinie Liczba postów: 125 Grupa: Trudne tema... A jeśli chodzi o firmy sprzątające nagrobki, to macie jakieś polecenia? Szukam na szybko kogoś sprawdzonego przed 1 listopada, bo niestety samemu ciężko wszystk...
- Taxi Warszawa Liczba postów: 2 Grupa: Trudne tema... Zastanawiałem się nad dorywczą pracą jako kierowca w weekendy, ale odrzucała mnie perspektywa zakładania firmy. Okazuje się, że są sposoby na ominięcie tej biur...







